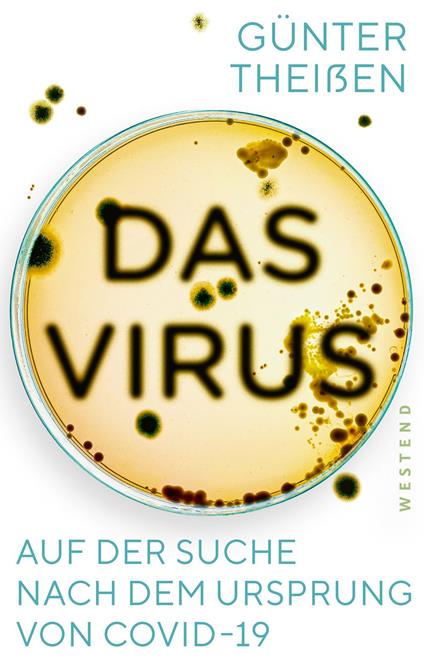

Das Virus
Natürliche Zoonose oder Laborunfall? COVID-19 hält seit über zwei Jahren die Welt in Atem. Doch wo liegt der Ursprung des Krankheit und wie genau ist es entstanden? Wie ein Kriminalkommissar hat sich der erfahrene Molekularbiologe Günter Theißen auf Spurensuche begeben und seit Anbeginn der Pandemie alle verfügbaren Fakten zusammengetragen. Schon bald musste er jedoch feststellen, dass sich die Mehrzahl der Fachleute und ein Großteil der Medien auf eine rein natürliche Entstehung des Virus festgelegt haben - ohne hieb- und stichfeste Beweise! Warum besteht so wenig Interesse an Aufklärung? Zusammen mit gleichgesinnten Kolleginnen und Kollegen setzt sich Theißen für eine vorurteilsfreie, faktenbasierte Diskussion über die Entstehung des Virus ein. Die Widerstände, auf die er dabei stößt, offenbaren akute Schwachstellen unserer Wissenschaftskultur, der Medienlandschaft und der internationalen Politik.
-
Autore:
-
Anno edizione:2022
-
Editore:
-
Formato:
-
Lingua:Tedesco
Formato:
Gli eBook venduti da Feltrinelli.it sono in formato ePub e possono essere protetti da Adobe DRM. In caso di download di un file protetto da DRM si otterrà un file in formato .acs, (Adobe Content Server Message), che dovrà essere aperto tramite Adobe Digital Editions e autorizzato tramite un account Adobe, prima di poter essere letto su pc o trasferito su dispositivi compatibili.
Cloud:
Gli eBook venduti da Feltrinelli.it sono sincronizzati automaticamente su tutti i client di lettura Kobo successivamente all’acquisto. Grazie al Cloud Kobo i progressi di lettura, le note, le evidenziazioni vengono salvati e sincronizzati automaticamente su tutti i dispositivi e le APP di lettura Kobo utilizzati per la lettura.
Clicca qui per sapere come scaricare gli ebook utilizzando un pc con sistema operativo Windows